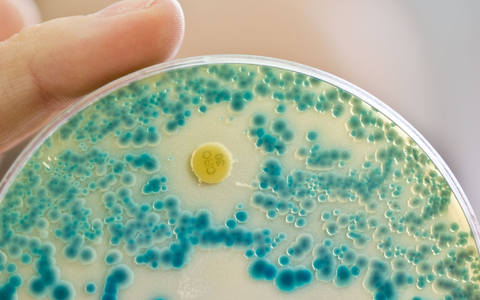
Indikatorkulturplatte zum Nachweis von resistenten Bakterien: Antibiotikaresistente Keime verursachen allein in der EU jÀhrlich Zehntausende TodesfÀlle. (Symbolbild) - Foto: Daniel Karmann/dpa Indikatorkulturplatte zum Nachweis von resistenten Bakterien: Antibiotikaresistente Keime verursachen allein in der EU jÀhrlich Zehntausende TodesfÀlle. (Symbolbild) - Foto: Daniel Karmann/dpa

Thema: Antibiotikaresistenzen
Homöopathie-Kampagne, Antibiotika-Krise

Homöopathie-Kampagne zielt auf Antibiotika-Krise - Foto: über boerse-global.de

Homöopathie-Kampagne zielt auf Antibiotika-Krise
boerse-global.de, 05.03.26 09:25 Uhr
Paratek, Aktie
In einer Phase ohne Unternehmensmeldungen richtet sich der ...
Paratek Aktie: Warten auf Impulse
boerse-global.de, 27.02.26 02:54 Uhr
Cambridge-Studie, Alltagschemikalien
Neue Forschung zeigt: Alltagschemikalien schädigen die ...
Cambridge-Studie schockt: 168 Alltagschemikalien zerstören Darmflora
boerse-global.de, 01.12.25 06:01 Uhr
WDR, Quarks
WDR Quarks: Was tun gegen Antibiotikaresistenzen?. Köln ...
WDR Quarks: Was tun gegen Antibiotikaresistenzen?
presseportal.de, 22.11.24 12:20 Uhr
Experten, Antibiotikaresistenzen
Experten alarmiert wegen Antibiotikaresistenzen. Und der ...
Alleine in der EU sterben jährlich Zehntausende Menschen an Infektionen durch antibiotikaresistente Erreger.
dpa.de, 17.10.24 10:00 Uhr
Antibiotikaresistenzen, Gefährliches
Antibiotikaresistenzen: Gefährliches bakterielles Resistenzgen ...
Eschborn - Die Behandlung von Infektionen, die durch antibiotikaresistente Keime verursacht werden, bereitet Wissenschaftlern zunehmend große Probleme.
presseportal.de, 02.05.24 10:00 Uhr
Gesundheit, Studie
Studie: Zahlreiche Todesfälle wegen Antibiotikaresistenzen ...





